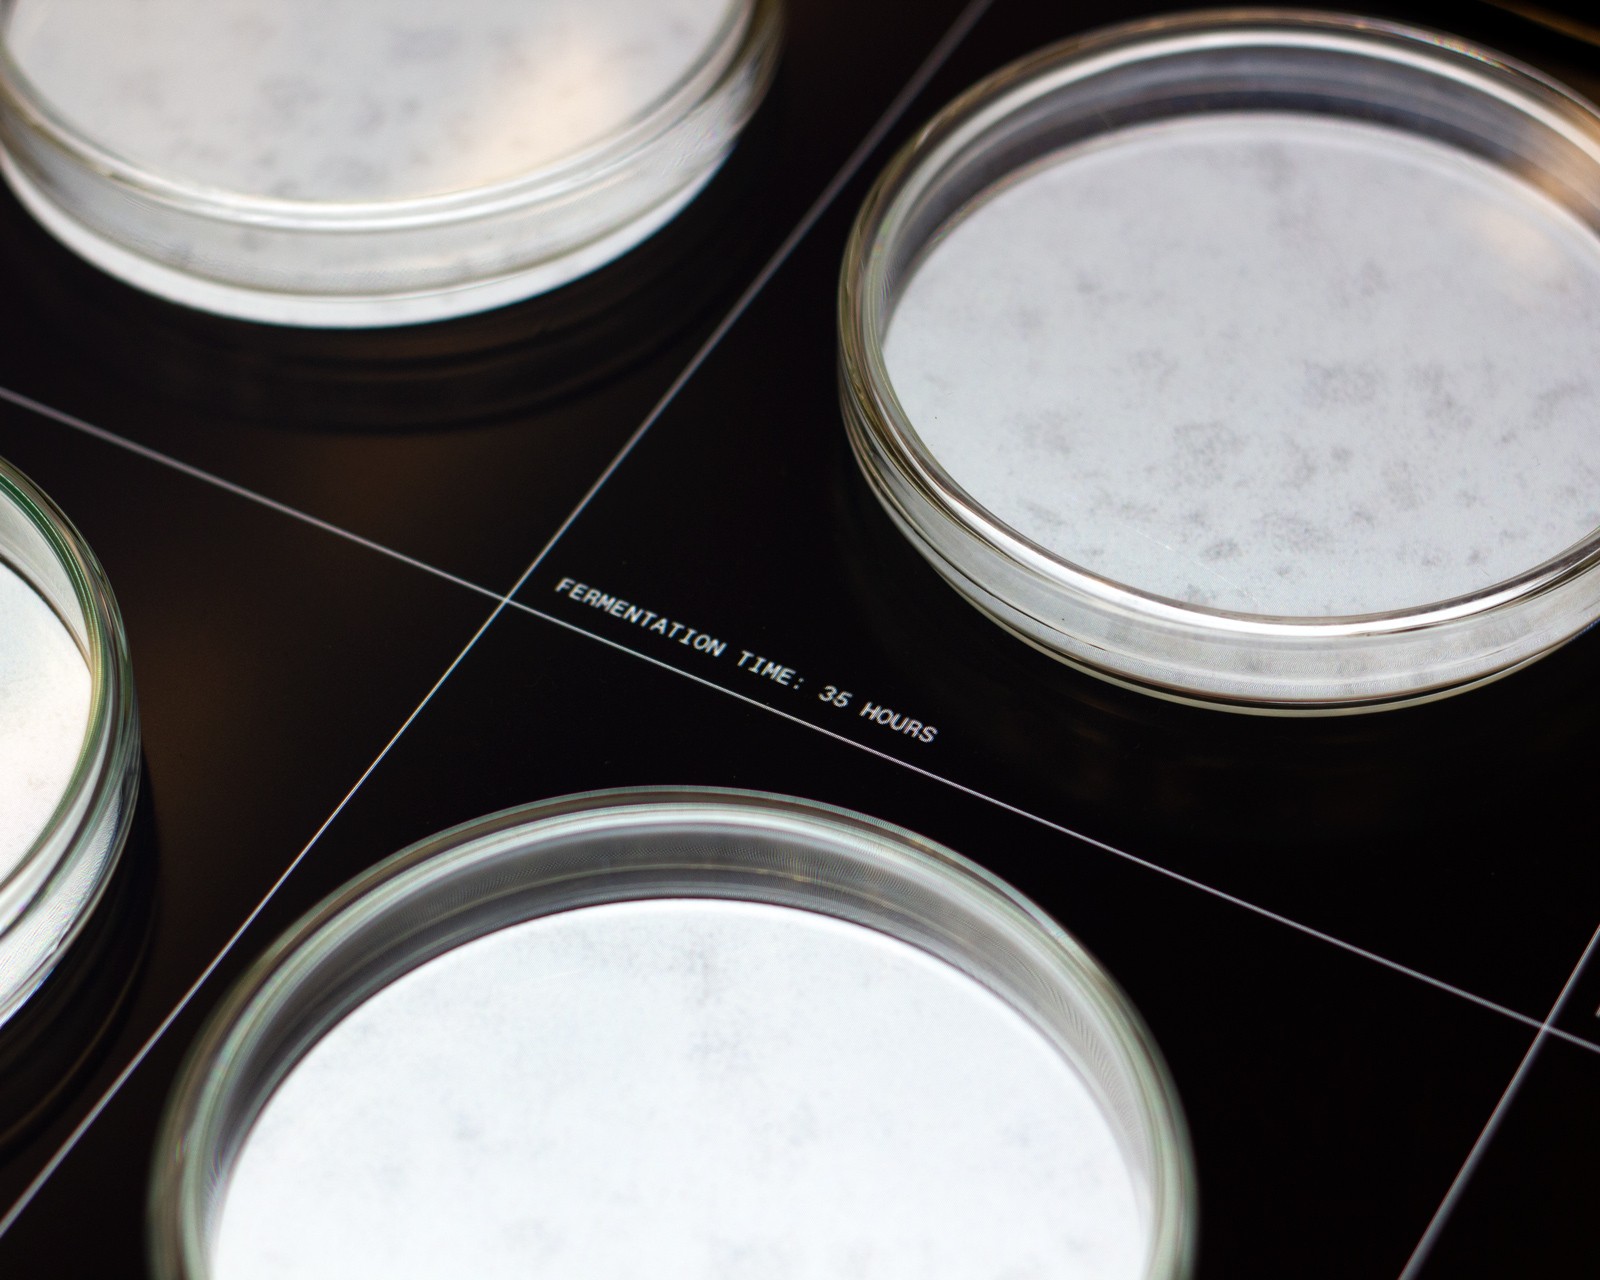
img_1208-w.jpg

Fixing the Future 2023

Introducing the fermenter at the Fixing The Future event at Barcelona’s Design Museum, a three days event of panel discussions, debates, workshops and performances that brought together 25 future-shaping projects from across the world. It was very rewarding for us to be in this environment where we’re all going in the same direction.

